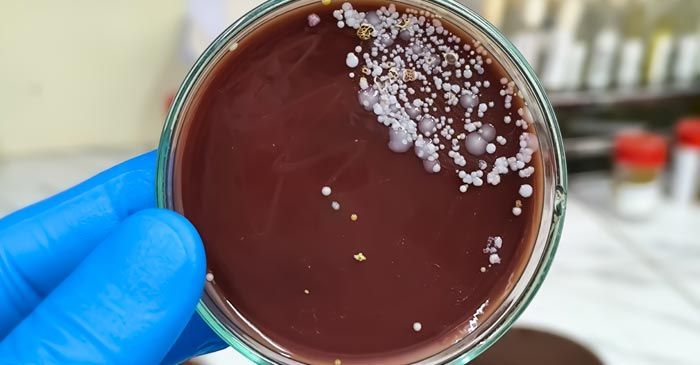
Petri dish with brown agar and white bacterial colonies, held by a gloved hand. Candida Remedies - Dr. Louis Granirer, Holistic Chiropractor

Candida Remedies - Dr. Louis Granirer, Holistic Chiropractor
"Candida organisms release more than 70 known toxins that accumulate in the joints, spinal fluid, and soft tissue. I can help you to overcome this health problem and educate you on ways to protect yourself from getting it back."
-Dr. Louis Granirer
NY Chiropractor
Candida Remedy in Kingston, Ulster County NY 12401
Candida is a highly adaptable fungus that is part of the majority of people's gut flora. It is normal to have a small amount. Problems arise for the individual when Candida becomes excessive. Candida albicans is the most common form of yeast infection that causes related medical conditions. The effects of chronic and systemic candidiasis are not fully understood, however, infections have been linked to chronic fatigue, Fibromyalgia, irritable bowel syndrome, ADD, and many other conditions.
Contact Dr. Louis Granirer
NY Holistic Chiropractor and Leading
Nutrition Response Testing Practitioner
For a Free Consultation
Since the mid 1990s, researchers at Stanford University, MIT, and Harvard have been mapping genomes of the common Candida albicans fungus. Decades of innovative DNA research have changed the way scientists view and treat candida. To evolve and thrive, the fungus is constantly mutating its gene sequences. Candida is capable of spontaneously rearranging data, deleting gene patterns, and changing chromosomal repeats similar to the way computers rapidly handle and exchange data packets.
Causes of Candida
Commensal organisms like candida are parasitic, which means the fungus lives and feeds, causing harm to the host. When the healthy bacterial balance is thrown off, the opportunistic candida takes advantage of the situation causing a fungal overgrowth. When candida gains a foothold in this manner, it dominates the intestinal microflora and prevents beneficial organisms from reestablishing themselves. If left unchecked, candida infections can become systemic and enter the bloodstream.
Severe candida overgrowth causes the fungus to penetrate the membranes of the intestinal lining where it can compromise the function of the body. By moving through the membrane, the Candida creates microscope pores in the intestines that can contribute to leaky gut syndrome and other conditions. Most cases of Candida are caused by C. albicans, however, infections with C. glabrata are gaining prevalence due to the species' vigor and resistance.
There are many causes of candidiasis and fungal overgrowth, such as repeated antibiotic use, poor diet, steroid medications, birth control pills, drugs, etc. Fungus can also be passed by the saliva and sexual activity. Generally, if one person has Candida, and they are in a relationship, then their partner may have excess Candida as well.
The overuse of antibiotics is a major contributor to fungal and Candida problems. Antibiotics kill the good as well as the bad bacteria. We all have a small amount of fungus in our gut, but the good bacteria can usually keep it in check. When antibiotics kill the good bacteria in our systems, then the fungus has an opportunity to take over the gut. It is so important to take probiotics, and an anti-fungal natural supplement, while you are on antibiotics to avoid fungal overgrowth. It is vital to make sure the anti-fungal supplement doesn't have any contraindications with the antibiotic.
Candida Symptoms
Symptoms of candidiasis and fungal problems include:
- chronic fatigue
- depression
- yeast infections
- bloating, joint or muscle pain
- anxiety
- hyperactivity
- food sensitivities
- hair loss
- foggy brain
- inability to concentrate
- consistent colds
- poorly functioning immune system
- rashes and acne
- sleep disturbances
- back pain
- moodiness and emotional swings
- feelings of being overwhelmed
- lack of clarity
- nasal congestion
- recurring sinusitis
- ear infections
- heartburn
- dark circles under the eyes
- sugar or vinegar cravings
- prostatitis
- bad breath
- hyperthyroidism
- environmental sensitivities
- chronic constipation or diarrhea
- itchy scalp or skin
- and many other symptoms

Natural Remedy for Candida
If you are experiencing any the above symptoms for an extended period of time, please contact me for a free consultation. Just because you experience several of the symptoms, it doesn’t mean you have Candida.
The only way to for me to provide healing solutions, and begin a plan of action to make you feel better, is to begin with an office visit. I started the Holistic Chiropractic Center based on providing you with highly personalized care for the entire duration of your therapy.
I specialize in healing solutions for Candida, which may be used in combination with other holistic healing services, to provide you with effective therapies.
- Nutrition Response Testing may be used to help heal the body from within. It is a healing and preventative therapy that contributes to overall feelings of wellness and restores your energy by properly fueling the organs in your body.
A Patient Case Study for Candida Remedies
Kimberly was a 30 year old woman who came into my office looking for help with gas and bloating issues. Kimberly had 2 miscarriages within the last two years and new that something in her body was off, but she couldn't figure out what it was. All of her medical tests came back normal.
She thought that it could be some form of food sensitivity, so she cut out gluten and dairy before our initial visit. Eliminating gluten and dairy helped her with the gas symptoms that she was having, but she still had severe bloating.
Using nutritional muscle testing techniques, I analyzed Kimberly and she muscle tested positive for the mixed Candida vial. Other food sensitivities were identified like soy, solanine, and dairy. Gluten seemed to test neutral.
I used a desensitization laser technique for the foods and the Candida. Kimberly went on an anti-candida protocol and was taken off her food sensitivities. She was also tested to see what anti-Candida supplements would change her reflexes and affect her autonomic nervous system. She tested for 4 antimicrobial and anti-Candida supplements. She also tested for a supplement for hypercoagulation and drainage, two very important factors to eradicate candida from the body.
After 21 days, the mixed candida vial no longer tested positive. Kimberly was candida free. Her bloating had decreased by 95 percent and her gas by 90 percent. She also indicated that her thinking was clearer, she had less redness to her skin, her moods were more balanced, her sugar carvings had disappeared, she was less hungry all the time, her energy had increased substantially, and she was sleeping better than she had in years.
Four weeks after completing her anti-candida protocol, Kimberly was pregnant. This time she went full term and gave birth to a very healthy boy. Her body was cleared of toxicity, candida, and hypercoagulation, which in turn allowed her body the ability to support a full term pregnancy.
Contact Hudson Valley Chiropractor Dr. Louis Granirer for Natural Remedies for Candida
Contact Dr. Louis Granirer today.



